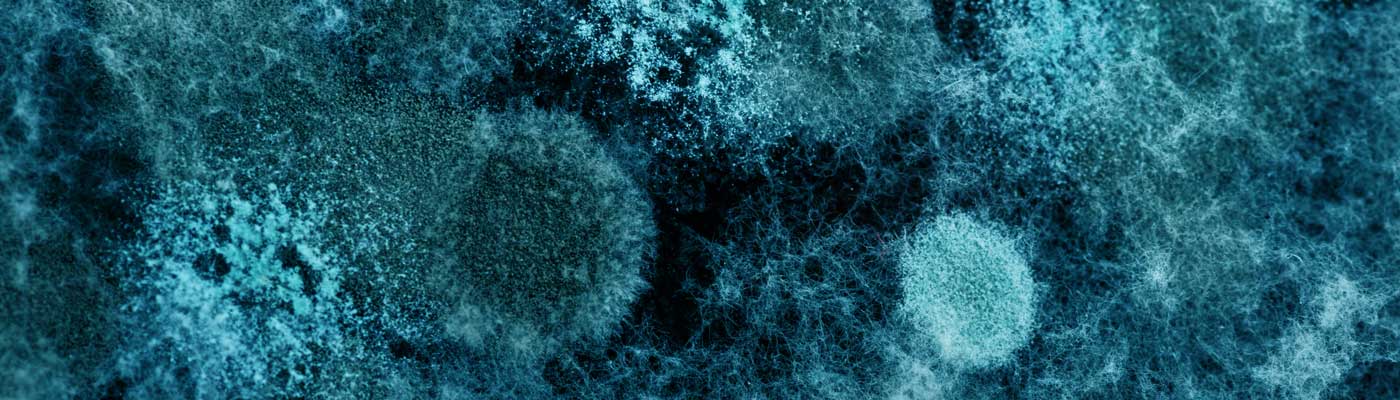
Infectious Diseases

Respiratory illness surveillance
Having trouble viewing this dashboard? View in a new window for best results.
Frequently asked questions
What is a respiratory infection?
Many respiratory infections have the same symptoms but can cause very different illnesses and outcomes. No matter what the respiratory illness is, there are actions that can be taken to help keep yourself and others healthy and stop the spread of respiratory illness. Learn prevention tips and view a list of symptoms by visiting our preventing the spread of respiratory infections page.
What does being at high risk mean and what precautions should I take?
The dashboard measures the risk of transmission of respiratory viruses in the whole region. Transmission of viruses refers to the spread of viruses from one person to another. The dashboard does not determine your personal risk of illness from respiratory viruses.
Many people are infected with respiratory viruses each year. Some infections, like influenza or COVID-19, can cause serious illness which can lead to hospitalization and death. The risk of serious illness is higher for very young children and older adults, or those who have other health conditions. More detailed information about what viruses may be spreading in the region can be found on the Overall surveillance tab of the dashboard.
Periods where the risk of transmission for respiratory viruses is high happen every year, especially from December through February. During these periods, it is important to take actions that can lower the chance that you or those around you may become sick with a respiratory illness. Use as many of these actions as you can, as often as you can.
- Get immunized.
- Wear a mask.
- Clean your hands.
- Cover your coughs and sneezes.
- Stay home when you are sick.
- Stay away from people who are at higher risk for serious illness.
- Notify people that might have been exposed.
- Improve ventilation and air filtration.
For more detailed information, please go to our preventing the spread of respiratory infections page.
If we are low risk in the Southeast Public Health region does that mean we don't have to take precautions?
Even if we are in a period of low risk, it does not mean zero risk. Taking steps to prevent respiratory illness should be a year-round consideration.
- Wash your hands often and avoid touching your eyes, nose or mouth with unwashed hands.
- Get your annual flu shot and get any COVID-19 boosters you are eligible for.
- Cover your mouth and nose when you cough or sneeze.
- Disinfect high-touch surfaces in your home and workplace.
- Wear a mask to protect yourself from viral respiratory illnesses. When you’re recovering from a respiratory illness, wear a mask to protect others who have a higher risk of infection.
- Stay home when you are feeling unwell to prevent the spread of illness to others.
What indicators determine high risk versus low risk?
Four indicators are used to determine if the Southeast Public Health region is in a period of high or low risk for respiratory illness transmission:
- percent positivity for COVID-19, influenza, and RSV
- respiratory-related emergency department (ED) visits
- active respiratory hospitalizations
- active respiratory outbreaks
More surveillance information for all indicators other than emergency department visits can be found in the Notes tab. Find additional surveillance information about respiratory-related emergency department visits on our viral respiratory illness mapper.
What are does the Southeast Public Health region include, and how do the indicators reflect what's happening there?
Southeast Public Health serves:
- Hastings County
- Prince Edward County
- The City of Kingston
- The County of Lennox & Addington
- The County of Frontenac
- The United Counties of Leeds and Grenville
- Lanark County
The indicators included in the dashboard include data from as much of the region as possible:
- Outbreaks include all institutions in the region.
- Active respiratory hospitalizations include hospitalizations at acute care hospitals in the region.
- Respiratory-related emergency department visits include all hospitals in the region except Almonte General Hospital.
- Currently, percent positivity only includes data from Kingston Health Sciences Centre, Lennox & Addington County General Hospital, Brockville General Hospital, and Perth and Smiths Falls District Hospital. Percent positivity data from the whole region is available from Public Health Ontario’s Ontario Respiratory Virus Tool. Please note data in this tool uses different data sources and there is a reporting delay compared to the Southeast Public Health respiratory dashboard.
The dashboard is presented for the whole region only. Generally, trends in the transmission of respiratory viruses are similar across the whole region. The indicators are also more stable when representing a larger population.
When is an outbreak declared?
There are two definitions that could be met for an outbreak to be declared in an institution (hospital, long-term care facility or retirement home):
- Two or more residents or patients who have tested positive for acute respiratory infections (ARI), with symptom onset within 48 hours and any common epidemiological link (e.g., unit, floor) that suggests transmission within the setting.
or
- Three or more cases of acute respiratory infections (laboratory confirmation not necessary) with symptom onset within 48 hours and any common epidemiological link (e.g., unit, floor), even if testing is not available or negative.
When is the dashboard updated?
The dashboard is updated to reflect the last complete “flu week” as defined by the Public Health Agency of Canada. Flu weeks run from Sunday to Saturday. Due to delays in some data sources, the dashboard is updated on Tuesday to reflect the previous week.
The Hospitalizations and Outbreaks tabs will show the data from the publishing date rather than the last complete week. Hospitalization data is from the Ministry of Health and there may be delays in reporting. In this case the dashboard will be updated when more data becomes available.
